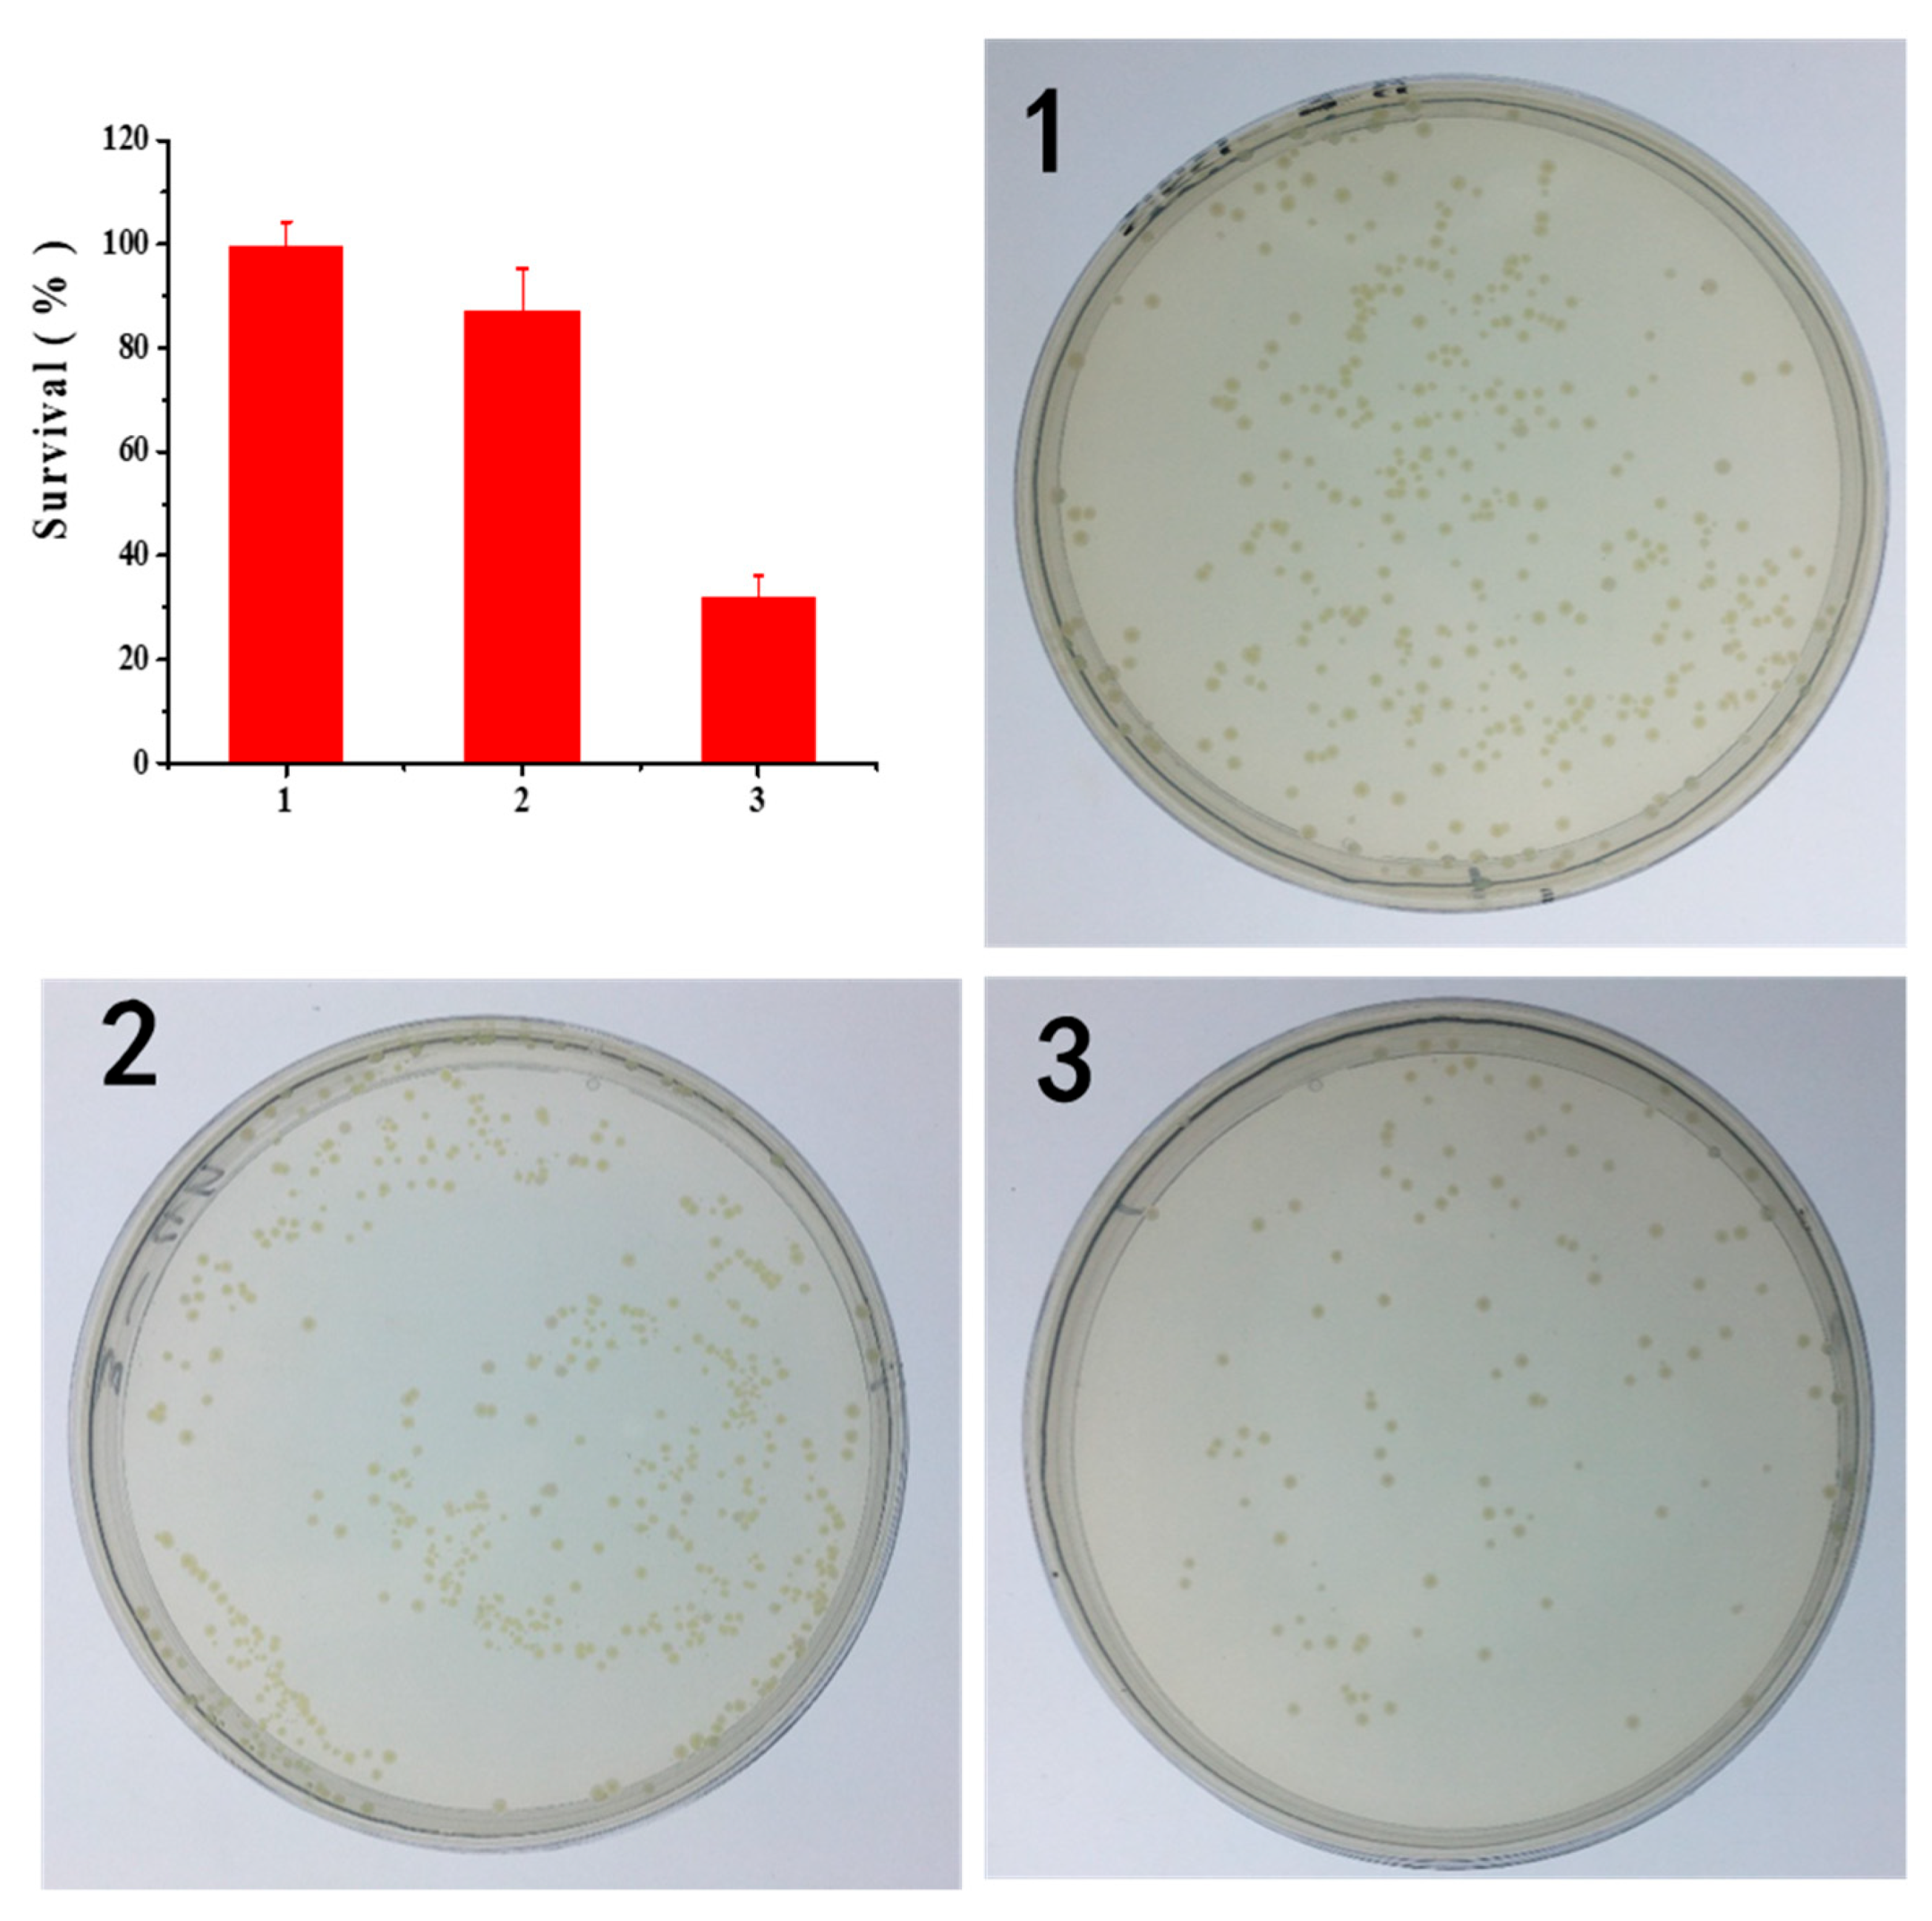

Physicochemical and Antibacterial Evaluation of TiO2/CNT Mesoporous Nanomaterials Prepared by High-Pressure Hydrothermal Sol–Gel Method under an Ultrasonic Composite Environment
Abstract
1. Introduction
2. Experimental Procedure
2.1. Materials and Methods
2.2. Performance and Characterization
3. Results and Discussion
4. Conclusions
Author Contributions
Funding
Institutional Review Board Statement
Informed Consent Statement
Data Availability Statement
Conflicts of Interest
Sample Availability
References
- Li, H.L.; Luo, S.W.; Zhang, L.Q.; Zhao, Z.L.; Wu, M.; Li, W.H.; Liu, F.Q. Water- and Acid-Sensitive Cu2O@Cu-MOF Nano Sustained-Release Capsules with Superior Antifouling Behaviors. Acs. Appl. Mater. Interfaces 2022, 14, 1910–1920. [Google Scholar] [CrossRef] [PubMed]
- Pan, J.; Liu, G.; Lu, G.M.; Cheng, H.M. On the True Photoreactivity Order of {001}, {010}, and {101} Facets of Anatase TiO2 Crystals. Angew. Chem. Int. Edit. 2011, 50, 2133–2137. [Google Scholar] [CrossRef] [PubMed]
- Zhao, Z.L.; Li, H.L.; Huang, L.X.; Tan, Y.; Liu, F.Q.; Li, W.H. Preparation of graphene quantum dots-doped TiO2 nanocomposites via a sol-gel method for photocathodic protection. Mol. Cryst. Liq. Cryst. 2021, 731, 80–87. [Google Scholar] [CrossRef]
- Li, J.; Bai, H.; Feng, Z. Advances in the Modification of Silane-Based Sol-Gel Coating to Improve the Corrosion Resistance of Magnesium Alloys. Molecules 2023, 28, 2563. [Google Scholar] [CrossRef] [PubMed]
- Geng, W.; Wang, L.; Yang, X.-Y. Nanocell hybrids for green chemistry. Trends Biotechnol. 2022, 40, 974–986. [Google Scholar] [CrossRef]
- Zhao, Z.L.; Zhuang, Y.L.; Wang, T.; Zhao, D.S.; Wu, X. Influence of Al-Si eutectic alloy on the mechanical behaviors and microstructure feature of ultralight dual-phase Mg-8Li-x(Al-12.6 Si) alloys. Mater. Today Commun. 2022, 30, 103201. [Google Scholar] [CrossRef]
- Zhao, Z.L.; Liu, Y.D.; Zhong, Y.F.; Chen, X.H.; Zhang, Z.Q. Corrosion Resistance of as-rolled Mg-Li-AlSi Alloys. Int. J. Electrochem. Sci. 2018, 13, 4338–4349. [Google Scholar] [CrossRef]
- Zhao, Z.L.; Li, Y.H.; Zhong, Y.F.; Liu, Y.D. Corrosion Performance of as-rolled Mg-8Li-xAl Alloys. Int. J. Electrochem. Sci. 2019, 14, 6394–6405. [Google Scholar] [CrossRef]
- Xue, S.-G.; Tang, L.; Tang, T.; Zhang, F.; Lyu, H.-G.; Liu, H.-Y.; Jiang, J.; Huang, Y.-H. Identifying the active sites in C-N codoped TiO2 electrode for electrocatalytic water oxidation to produce H2O2. J. Cent. South Univ. 2022, 29, 3016–3029. [Google Scholar] [CrossRef]
- Wang, Y.; Zhao, X.; Zheng, Z.; Jiang, H.; Chen, T.; Zhang, Y.; Cao, H.; Lin, H.; Zhan, R. Pd-M-TiO2 (M=Mn, Cu, Ce and Fe) as passive NOx adsorber (PNA) at low temperature. J. Cent. South Univ. 2022, 29, 2253–2265. [Google Scholar] [CrossRef]
- Zada, A.; Ali, N.; Subhan, F.; Anwar, N.; Ali Shah, M.I.; Ateeq, M.; Hussain, Z.; Zaman, K.; Khan, M. Suitable energy platform significantly improves charge separation of g-C3N4 for CO2 reduction and pollutant oxidation under visible-light. Prog. Nat. Sci. Mater. Int. 2019, 29, 138–144. [Google Scholar] [CrossRef]
- Hao, D.; Liu, Y.; Gao, S.; Arandiyan, H.; Bai, X.; Kong, Q.; Wei, W.; Shen, P.K.; Ni, B.-J. Emerging artificial nitrogen cycle processes through novel electrochemical and photochemical synthesis. Mater. Today 2021, 46, 212–233. [Google Scholar] [CrossRef]
- Rade, P.P.; Giram, P.S.; Shitole, A.A.; Sharma, N.; Garnaik, B. Physicochemical and in Vitro Antibacterial Evaluation of Metronidazole Loaded Eudragit S-100 Nanofibrous Mats for the Intestinal Drug Delivery. Adv. Fiber Mater. 2022, 4, 76–88. [Google Scholar] [CrossRef]
- Wang, S.; Li, J.; Cao, Y.; Gu, J.; Wang, Y.; Chen, S. Non-Leaching, Rapid Bactericidal and Biocompatible Polyester Fabrics Finished with Benzophenone Terminated N-halamine. Adv. Fiber Mater. 2022, 4, 119–128. [Google Scholar] [CrossRef]
- Du, Y.; Hao, Q.; Chen, D.; Chen, T.; Hao, S.; Yang, J.; Ding, H.; Yao, W.; Song, J. Facile fabrication of heterostructured bismuth titanate nanocomposites: The effects of composition and band gap structure on the photocatalytic activity performance. Catal. Today 2017, 297, 255–263. [Google Scholar] [CrossRef]
- Tripathy, J.; Lee, K.; Schmuki, P. Tuning the Selectivity of Photocatalytic Synthetic Reactions Using Modified TiO2 Nanotubes. Angew. Chem. Int. Ed. 2014, 53, 12605–12608. [Google Scholar] [CrossRef]
- Lee, S.S.; Bai, H.; Liu, Z.; Sun, D.D. Novel-structured electrospun TiO2/CuO composite nanofibers for high efficient photocatalytic cogeneration of clean water and energy from dye wastewater. Water Res. 2013, 47, 4059–4073. [Google Scholar] [CrossRef]
- Tang, C.; Bai, H.; Liu, L.; Zan, X.; Gao, P.; Sun, D.D.; Yan, W. A green approach assembled multifunctional Ag/AgBr/TNF membrane for clean water production & disinfection of bacteria through utilizing visible light. Appl. Catal. B Environ. 2016, 196, 57–67. [Google Scholar] [CrossRef]
- Zhao, Z.; Jiang, X.; Li, S.; Li, L.; Feng, Z.; Lai, H. Microstructure Characterization and Battery Performance Comparison of MOF-235 and TiO2-P25 Materials. Crystals 2022, 12, 152. [Google Scholar] [CrossRef]
- Zheng, H.; Guo, Y.-C.; Shen, F.-M. Production of titanium powder by metallothermic reduction of TiO2 in cold pressed pellets. J. Cent. South Univ. 2021, 28, 48–57. [Google Scholar] [CrossRef]
- Zouheir, M.; Tanji, K.; Navio, J.A.; Hidalgo, M.C.; Jaramillo-Páez, C.A.; Kherbeche, A. Effective photocatalytic conversion of formic acid using iron, copper and sulphate doped TiO2. J. Cent. South Univ. 2022, 29, 3592–3607. [Google Scholar] [CrossRef]
- Yang, F.; Wen, L.; Peng, Q.; Zhao, Y.; Xu, J.; Hu, M.; Zhang, S.; Yang, Z. Prediction of structural and electronic properties of Cl2 adsorbed on TiO2(100) surface with C or CO in fluidized chlorination process: A first-principles study. J. Cent. South Univ. 2021, 28, 29–38. [Google Scholar] [CrossRef]
- Fan, B.; Liu, H.; Wang, Z.; Zhao, Y.; Yang, S.; Lyu, S.; Xing, A.; Zhang, J.; Li, H.; Liu, X. Ferroelectric polarization-enhanced photocatalytic performance of heterostructured BaTiO3@TiO2 via interface engineering. J. Cent. South Univ. 2021, 28, 3778–3789. [Google Scholar] [CrossRef]
- Xiang, J.; Wang, S.C.; Cao, Y.X.; Fang, L.N.; Ke, W.; Guo, H.; Duan, B.Y.; Yu, W.H.; Li, L.; Zhao, Z.L. One-Step Preparation of High Performance TiO2/CNT/CQD Nanocomposites Bactericidal Coating with Ultrasonic Radiation. Coatings 2023, 13, 145. [Google Scholar] [CrossRef]
- Zhao, Z.; Lai, H.S.; Li, H.; Li, L. Preparation and Properties of Graphene Doped TiO2 Mesoporous Materials for Photocathode Protection. Int. J. Electrochem. Sci. 2021, 16, 210316. [Google Scholar] [CrossRef]
- Zada, A.; Khan, M.; Hussain, Z.; Shah, M.I.A.; Ateeq, M.; Ullah, M.; Ali, N.; Shaheen, S.; Yasmeen, H.; Ali Shah, S.N.; et al. Extended visible light driven photocatalytic hydrogen generation by electron induction from g-C3N4 nanosheets to ZnO through the proper heterojunction. Z. Phys. Chem. 2022, 236, 53–66. [Google Scholar] [CrossRef]
- Wang, Y.X.; Rao, L.; Wang, P.F.; Shi, Z.Y.; Zhang, L.X. Photocatalytic activity of N-TiO2/O-doped N vacancy g-C3N4 and the intermediates toxicity evaluation under tetracycline hydrochloride and Cr(VI) coexistence environment. Appl. Catal. B Environ. 2020, 262, 12. [Google Scholar] [CrossRef]
- Wang, C.J.; Zhao, Y.L.; Xu, H.; Li, Y.F.; Wei, Y.C.; Liu, J.; Zhao, Z. Efficient Z-scheme photocatalysts of ultrathin g-C3N4-wrapped Au/TiO2-nanocrystals for enhanced visible-light-driven conversion of CO2 with H2O. Appl. Catal. B Environ. 2020, 263, 13. [Google Scholar] [CrossRef]
- Zhao, J.; Zhang, J.L.; Wang, L.; Lyu, S.S.; Ye, W.L.; Xu, B.B.; Qiu, H.; Chen, L.X.; Gu, J.W. Fabrication and investigation on ternary heterogeneous MWCNT@TiO2-C fillers and their silicone rubber wave-absorbing composites. Compos. Part. A Appl. Sci. Manuf. 2020, 129, 8. [Google Scholar] [CrossRef]
- Zhou, W.; Sun, F.; Pan, K.; Tian, G.; Jiang, B.; Ren, Z.; Tian, C.; Fu, H. Well-Ordered Large-Pore Mesoporous Anatase TiO2 with Remarkably High Thermal Stability and Improved Crystallinity: Preparation, Characterization, and Photocatalytic Performance. Adv. Funct. Mater. 2011, 21, 1922–1930. [Google Scholar] [CrossRef]
- Zhou, W.; Li, W.; Wang, J.-Q.; Qu, Y.; Yang, Y.; Xie, Y.; Zhang, K.; Wang, L.; Fu, H.; Zhao, D. Ordered Mesoporous Black TiO2 as Highly Efficient Hydrogen Evolution Photocatalyst. J. Am. Chem. Soc. 2014, 136, 9280–9283. [Google Scholar] [CrossRef]
- Xu, H.M.; Liu, W.; Cao, L.X.; Su, G.; Duan, R.J. Preparation of porous TiO2/ZnO composite film and its photocathodic protection properties for 304 stainless steel. Appl. Surf. Sci. 2014, 301, 508–514. [Google Scholar] [CrossRef]
- Hu, G.; Xiao, Y.; Ying, J. Nano-SiO2 and Silane Coupling Agent Co-Decorated Graphene Oxides with Enhanced Anti-Corrosion Performance of Epoxy Composite Coatings. Int. J. Mol. Sci. 2021, 22, 11087. [Google Scholar] [CrossRef]
- Li, J.; Li, T.; Zeng, Y.; Chen, C.; Guo, H.; Lei, B.; Zhang, P.; Feng, Z.; Meng, G. A novel sol-gel coating via catechol/lysine polymerization for long-lasting corrosion protection of Mg alloy AZ31. Colloids Surf. A Physicochem. Eng. Asp. 2023, 656, 130361. [Google Scholar] [CrossRef]
- Ghicov, A.; Albu, S.P.; Hahn, R.; Kim, D.; Stergiopoulos, T.; Kunze, J.; Schiller, C.-A.; Falaras, P.; Schmuki, P. TiO2 Nanotubes in Dye-Sensitized Solar Cells: Critical Factors for the Conversion Efficiency. Chem. Asian J. 2009, 4, 520–525. [Google Scholar] [CrossRef]
- Lu, Y.; Cheng, X.; Tian, G.; Zhao, H.; He, L.; Hu, J.; Wu, S.-M.; Dong, Y.; Chang, G.-G.; Lenaerts, S.; et al. Hierarchical CdS/m-TiO2/G ternary photocatalyst for highly active visible light-induced hydrogen production from water splitting with high stability. Nano Energy 2018, 47, 8–17. [Google Scholar] [CrossRef]
- Nie, X.; Yin, S.; Duan, W.; Zhao, Z.; Li, L.; Zhang, Z. Recent Progress in Anodic Oxidation of TiO2 Nanotubes and Enhanced Photocatalytic Performance: A Short Review. Nano 2021, 16, 2130002. [Google Scholar] [CrossRef]
- Asahi, R.; Morikawa, T.; Ohwaki, T.; Aoki, K.; Taga, Y. Visible-light photocatalysis in nitrogen-doped titanium oxides. Science 2001, 293, 269–271. [Google Scholar] [CrossRef]
- Zheng, J.Y.; Lyu, Y.H.; Wang, R.L.; Xie, C.; Zhou, H.J.; Jiang, S.P.; Wang, S.Y. Crystalline TiO2 protective layer with graded oxygen defects for efficient and stable silicon-based photocathode. Nat. Commun. 2018, 9, 3572. [Google Scholar] [CrossRef]
- Wu, Q.; Liu, X.M.; Li, B.; Tan, L.; Han, Y.; Li, Z.Y.; Liang, Y.Q.; Cui, Z.D.; Zhu, S.L.; Wu, S.L.; et al. Eco-friendly and degradable red phosphorus nanoparticles for rapid microbial sterilization under visible light. J. Mater. Sci. Technol. 2021, 67, 70–79. [Google Scholar] [CrossRef]
- Avsec, K.; Conradi, M.; Jenko, M.; Kocjancic, B.; Debeljak, M.; Gorensek, M.; Dolinar, D. Effect of sterilization on the surface properties of ti6al7nb alloy femoral stems. Mater. Tehnol. 2021, 55, 59–64. [Google Scholar] [CrossRef]

Disclaimer/Publisher’s Note: The statements, opinions and data contained in all publications are solely those of the individual author(s) and contributor(s) and not of MDPI and/or the editor(s). MDPI and/or the editor(s) disclaim responsibility for any injury to people or property resulting from any ideas, methods, instructions or products referred to in the content. |
© 2023 by the authors. Licensee MDPI, Basel, Switzerland. This article is an open access article distributed under the terms and conditions of the Creative Commons Attribution (CC BY) license (https://creativecommons.org/licenses/by/4.0/).
Share and Cite
Lai, H.; Zhao, Z.; Yu, W.; Lin, Y.; Feng, Z. Physicochemical and Antibacterial Evaluation of TiO2/CNT Mesoporous Nanomaterials Prepared by High-Pressure Hydrothermal Sol–Gel Method under an Ultrasonic Composite Environment. Molecules 2023, 28, 3190. https://doi.org/10.3390/molecules28073190
Lai H, Zhao Z, Yu W, Lin Y, Feng Z. Physicochemical and Antibacterial Evaluation of TiO2/CNT Mesoporous Nanomaterials Prepared by High-Pressure Hydrothermal Sol–Gel Method under an Ultrasonic Composite Environment. Molecules. 2023; 28(7):3190. https://doi.org/10.3390/molecules28073190
Chicago/Turabian StyleLai, Huansheng, Zilong Zhao, Wenhe Yu, Yuan Lin, and Zhiyuan Feng. 2023. "Physicochemical and Antibacterial Evaluation of TiO2/CNT Mesoporous Nanomaterials Prepared by High-Pressure Hydrothermal Sol–Gel Method under an Ultrasonic Composite Environment" Molecules 28, no. 7: 3190. https://doi.org/10.3390/molecules28073190
APA StyleLai, H., Zhao, Z., Yu, W., Lin, Y., & Feng, Z. (2023). Physicochemical and Antibacterial Evaluation of TiO2/CNT Mesoporous Nanomaterials Prepared by High-Pressure Hydrothermal Sol–Gel Method under an Ultrasonic Composite Environment. Molecules, 28(7), 3190. https://doi.org/10.3390/molecules28073190

